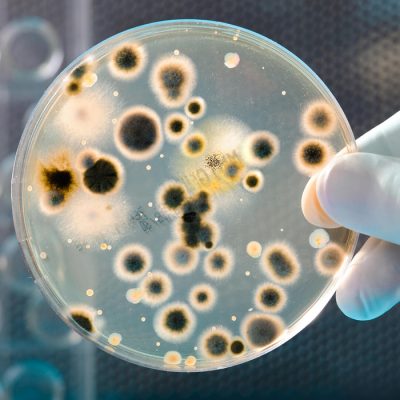

Dealing with a sewage backup in your home can be both stressful and overwhelming. However, it is crucial to understand the importance of proper sewage cleanup to protect your health and home. The Dry Guy Restoration offers the best sewage cleanup services learn more below, and contact us for a free estimate today!
Health Reasons
Health Reasons
First and foremost, sewage cleanup and toilet overflow cleanup are essential for health reasons. Sewage contains bacteria, viruses, fungi, and other microorganisms that can cause various diseases and infections. Exposure to these pathogens can lead to gastrointestinal issues, respiratory problems, skin infections, and more. Additionally, sewage backup can release dangerous gasses like methane and hydrogen sulfide, which can be harmful if inhaled in large quantities.

Sanitization
Proper sewage cleanup at your home or business involves not only removing the visible waste but also thoroughly sanitizing the affected area. This includes using appropriate cleaning agents and disinfectants to eliminate harmful pathogens and prevent the growth of mold and mildew. Professional sewage cleanup services have the knowledge, experience, and equipment to effectively clean and disinfect the contaminated areas, ensuring a safe and healthy living environment. Call today.

Structural Integrity of Your Building
Sewage and toilet backup can cause extensive damage to your property, including the foundation, walls, flooring, and electrical systems. The longer the contaminated water sits, the more it can seep into porous surfaces, leading to structural issues, corrosion, and even potential collapse. Immediate action and thorough cleanup from The Dry Guy Restoration are key to minimizing the damage and ensuring the long-term stability of your home.

Contains the Area
Lastly, addressing sewage backup promptly and professionally can help prevent further contamination and spreading of the sewage. Sewage backup can affect not only your home but also neighboring properties and the environment. By properly containing and cleaning up the sewage, you contribute to preventing the contamination of water sources, reducing the risk of waterborne diseases, and protecting the overall well-being of your community.
Get Started Today
Proper sewage cleanup is vital for protecting your health and home. It is not a task to be taken lightly or attempted without the necessary knowledge and expertise. Hiring professional sewage cleanup services ensures that the job is done thoroughly, efficiently, and safely, giving you peace of mind and a clean, healthy living environment. Call The Dry Guy Restoration today!
Get a Free Quote